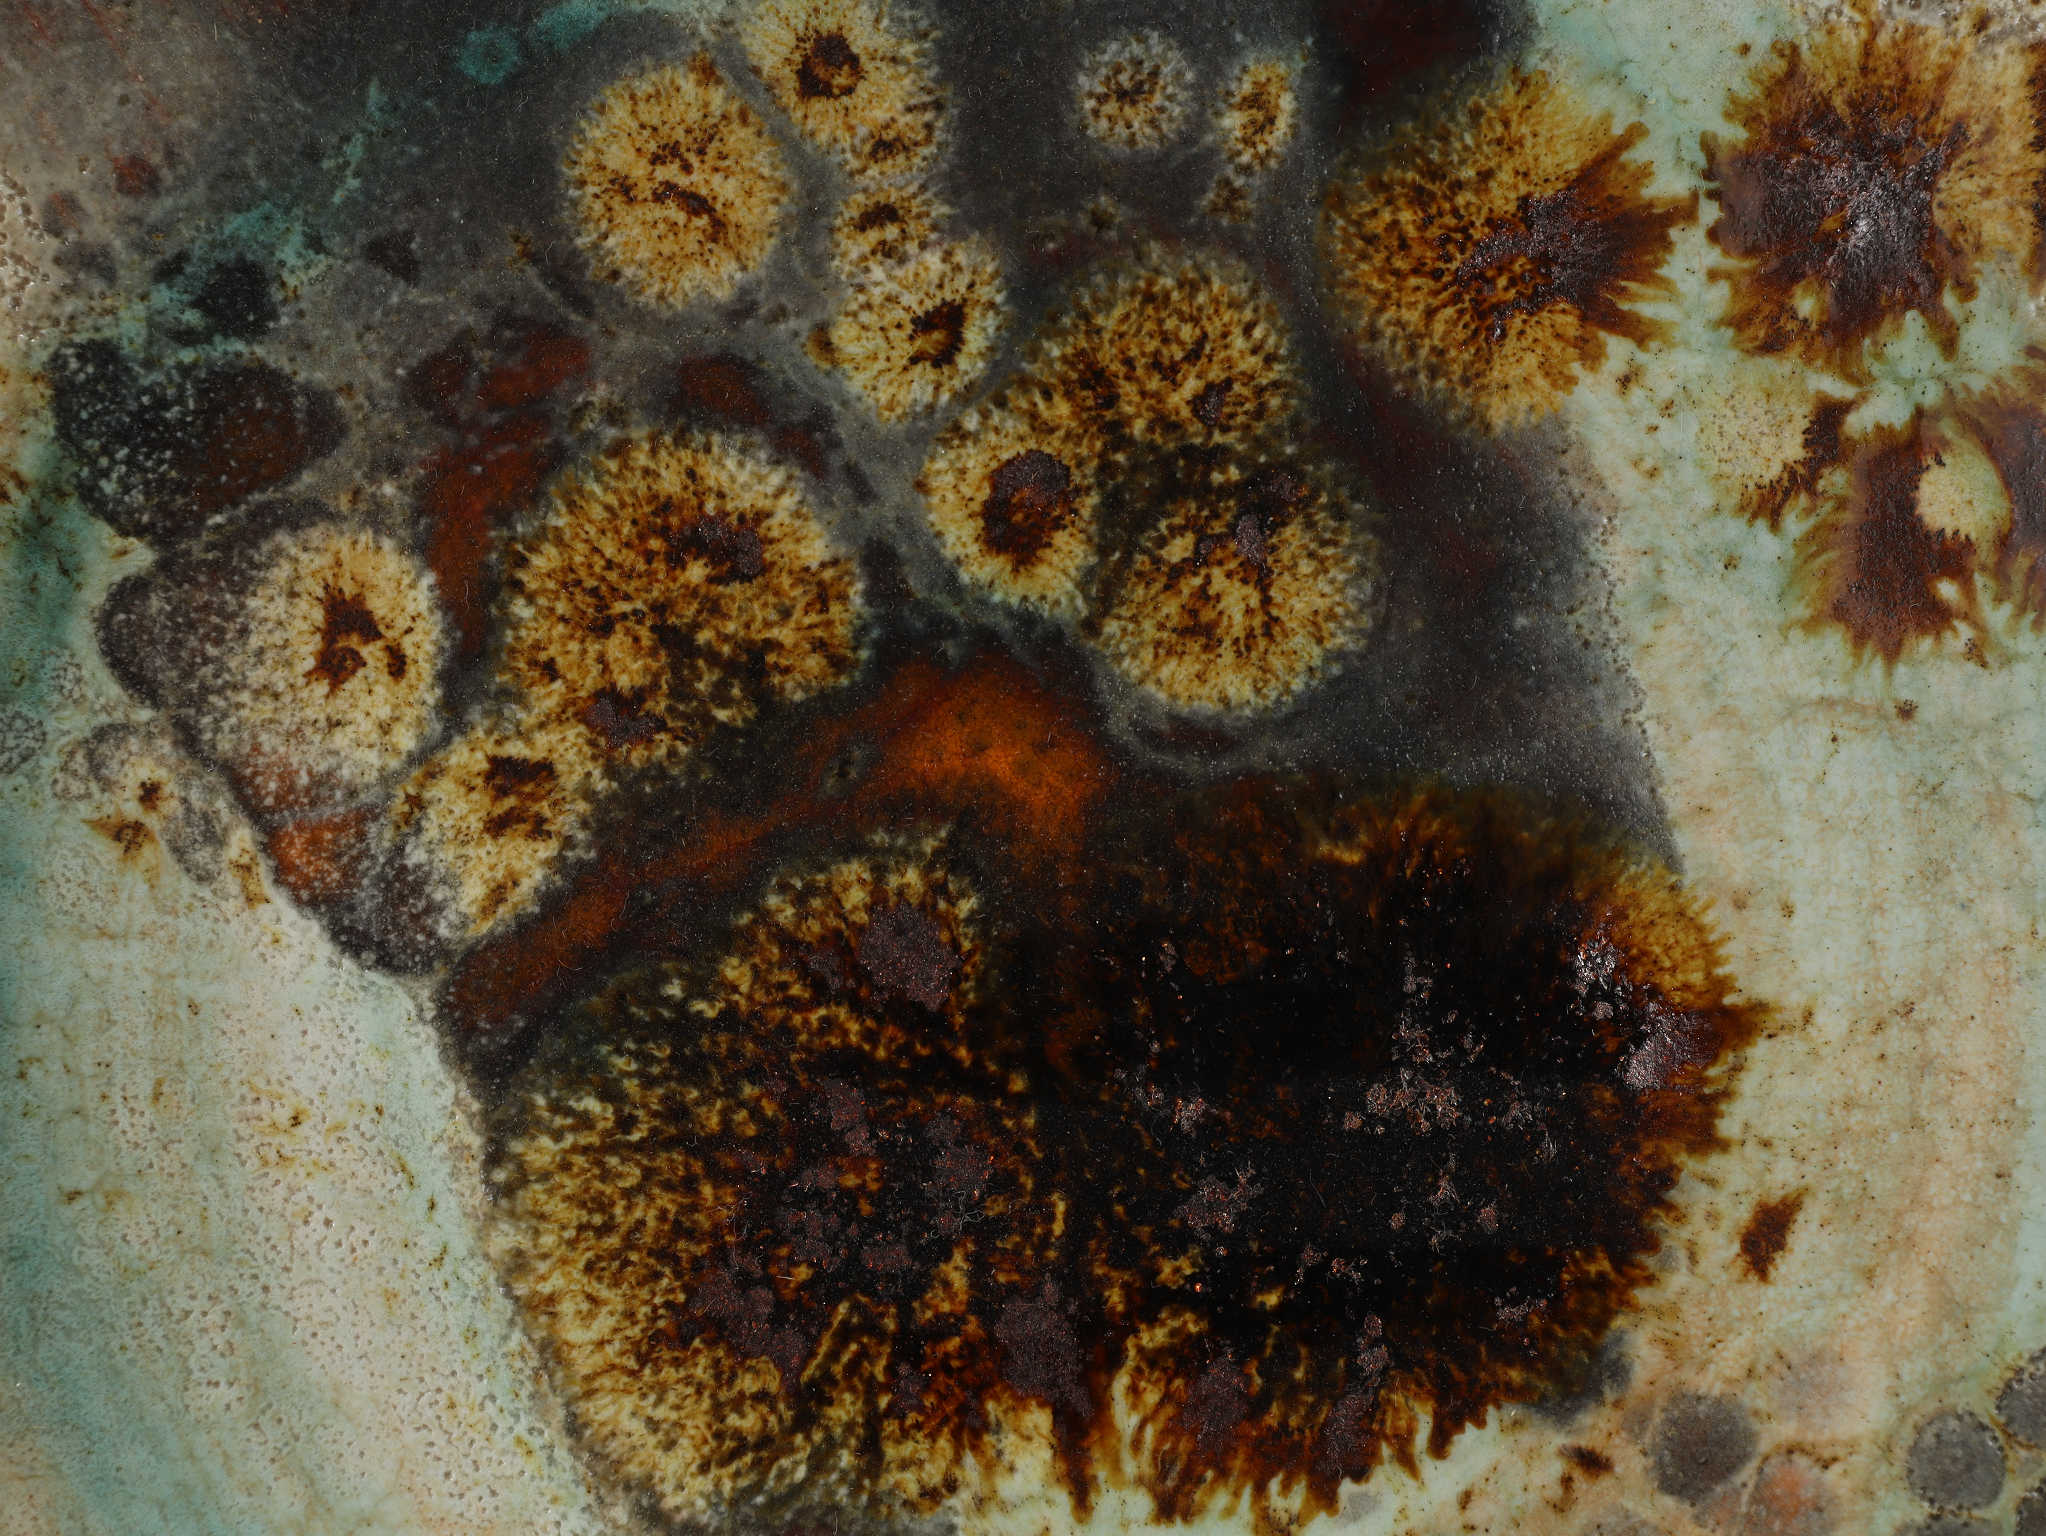

/
Ceramic Wall Art
セラミックウォールアート
SALE
Item ID:QL008130
本体価格:¥38,000 → ¥34,200
(税込価格:¥41,800 → ¥37,620)
在庫数量:1
Tel: 03-5708-5411 (10:30-18:30)
Tel: 03-5708-5411 (10:30-18:30)受取状況を読み込めませんでした
Tel: 03-5708-5411 (10:30-18:30)
Tel: 03-5708-5411 (10:30-18:30)受取状況を読み込めませんでした

※プリントにつき、実際のお色とは異なることがございます。
※アンティーク商品は現品限りとなる場合がございます。売り切れの際はご了承ください。